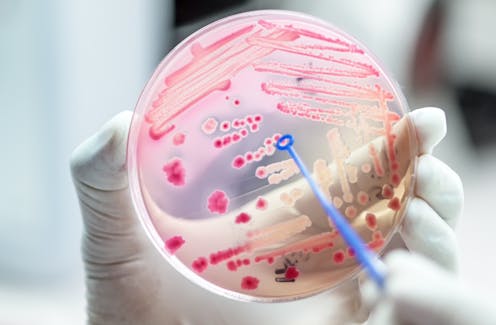

'Host-directed therapy' could treat infectious diseases – including COVID – and limit drug-resistance
- Written by Christian Doerig, Professor, RMIT University
Antibiotics, together with antivirals and anti-parasitic drugs, can save the lives of people who’ve contracted an infectious disease. But the rise of drug-resistance means new strategies are needed. At the end of last year, the World Health Organization declared[1] antimicrobial resistance one of the top ten global public health threats facing humanity.
To cause disease, all viruses – including SARS-CoV-2, which causes COVID – must enter our cells and hijack their machinery to reproduce. Likewise, many bacteria and parasites must invade our cells to survive.
One promising area of research is based on the idea that, rather than fighting the pathogen (or bug) itself, we can target enzymes (proteins in human cells that facilitate chemical reactions) it needs to live and multiply. This is called “host-directed therapy[2]”.
Our latest work suggests it could fight malaria[3] and viral infections[4]. Host-directed therapy could also help control pandemic diseases like COVID[5].
Read more: Antimicrobial resistance now causes more deaths than HIV/AIDS and malaria worldwide – new study[6]
When a solution became a problem
In the realm of infectious diseases, the mid-20th century brought a sense of euphoria. The newly discovered antibiotics were a dream weapon against bacteria, saving countless lives during the second world war, which would otherwise have been lost to infected wounds. Drugs targeting other pathogens such as malaria parasites also emerged in this period. One example is chloroquine[7], which was deployed to great effect in the 1950s and made malaria eradication a seemingly reachable objective.
Soon, however, the euphoria subsided. The first cases of bacteria with resistance to penicillin were reported in 1942, just two years after its mass deployment. Then chloroquine resistance in malaria parasites emerged in the 1950s, and soon this wonder drug became ineffective in many parts of the world.
In 2014, the World Health Organization published its first global report on antimicrobial resistance[8], highlighting concerns this could takes us back to the pre-antibiotic era with respect to bacterial, viral, fungal and parasitic infections.
Anti-infective drugs can rapidly elicit drug resistance. The virus, bacterium or parasite undergoes (by chance!) a mutation so the drug can’t bind to its target enzyme. Since the mutation allows the pathogen to reproduce even in the presence of the drug, the mutant microbe quickly outgrows and replaces the “normal” pathogens, which are all killed by the drug. (Incidentally, a similar phenomenon happens with the targets for vaccines, hence the “escape variants” that make the headlines).
Eventually, this leads to the establishment of drug-resistant disease.
Turning a strength into a weakness
The lifestyle of viruses and of many bacteria and parasites within cells helps them not only to evade of our immune system, but also to make use of the body’s enzymes inside our cells. For example, recent research has shown that as malaria parasites reproduce inside our red blood cells, they require the activity of enzymes[10] within the host cells to survive.
Host-directed therapy can help by turning the intracellular lifestyle of these pathogens into an Achilles’ heel.
As the infectious agent requires host cell enzymes for survival, we can kill it by using drugs that target host cell enzymes, instead of targeting the pathogen directly (like classical antibiotics do).
The advantage of this is that the new target of the drug is not encoded by the microbe’s DNA – so the pathogen can’t become resistant through a straightforward mutation in its target-encoding DNA. There are other ways for the bug to become resistant (for example, by developing a system that pumps the drug out), but this is not as immediate. So host-directed therapies may remain effective for longer.
Read more: Have Australian researchers developed an effective COVID-19 treatment? Potentially, but we need to wait for human trials[11]
Several bugs, one therapy?
Another advantage is that many of the host cell enzymes the pathogens need to survive are the same as those that are overactive in other diseases.
One example is the “kinase” family of enzymes. These enzymes are often overactive in cancers and there are more than 70 approved drugs that kill cancer cells by blocking kinases[12].
We and others tested some of these anticancer agents on malaria-infected red blood cells, and found them very effective at killing the parasite[13].
Of course, killing pathogens using drugs to block human enzymes raises the problem of secondary effects. We don’t want host-directed therapies to cause problems for the host. This can be alleviated by drug repurposing: using known drugs that already have a good safety profile in clinical trials.
Read more: The fight against TB shifts to fixing the immune system, not only bacteria[16]
In some cases, the same host cell kinase is important for the survival of several different bugs. So host-directed drugs with broad-spectrum properties could treat more than one disease and streamline treatment strategies.
Besides the ongoing antimicrobial resistance crisis, the emergence of new infectious diseases occurs repeatedly, as with COVID – a painful and stark reminder that infectious diseases are far from a solved problem. Host-directed therapies may bring a much-needed contribution to the ongoing fight against diseases, while limiting the emergence of drug resistance.
References
- ^ declared (www.who.int)
- ^ host-directed therapy (pubmed.ncbi.nlm.nih.gov)
- ^ malaria (www.nature.com)
- ^ viral infections (www.nature.com)
- ^ COVID (www.sciencedirect.com)
- ^ Antimicrobial resistance now causes more deaths than HIV/AIDS and malaria worldwide – new study (theconversation.com)
- ^ chloroquine (medlineplus.gov)
- ^ report on antimicrobial resistance (www.who.int)
- ^ Shutterstock (image.shutterstock.com)
- ^ require the activity of enzymes (www.nature.com)
- ^ Have Australian researchers developed an effective COVID-19 treatment? Potentially, but we need to wait for human trials (theconversation.com)
- ^ more than 70 approved drugs that kill cancer cells by blocking kinases (www.nature.com)
- ^ killing the parasite (www.cell.com)
- ^ Adam Nieścioruk/Unsplash (images.unsplash.com)
- ^ CC BY (creativecommons.org)
- ^ The fight against TB shifts to fixing the immune system, not only bacteria (theconversation.com)